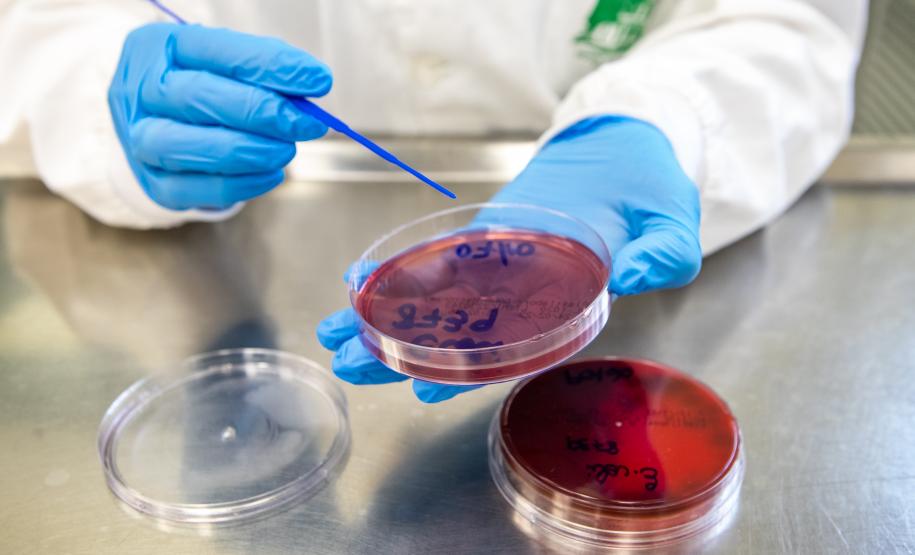
Prestes a superar marca de 2023, Lacen ultrapassa meio milhão de exames em 2024

Prestes a superar marca de 2023, Lacen ultrapassa meio milhão de exames em 2024 08/10/2024 - 16:00
O Laboratório Central do Paraná (Lacen-PR), pertencente à Secretaria da Saúde do Paraná (Sesa), passou a marca de meio milhão de exames realizados desde janeiro e até esta primeira semana de outubro. Foram exatas 568.537 análises na unidade, que faz um trabalho preciso e de referência nacional, com mais de 50 tipos de testagem voltados à vigilância epidemiológica e ao monitoramento de doenças infecciosas de notificação obrigatória.
O número alcançado até agora ano já é praticamente igual ao registrado durante todo o ano de 2023, que fechou com 568.701 exames. “Protagonismo, quantidade e qualidade andam juntas no Lacen, resultando em um trabalho referenciado e de grande relevância para a saúde pública”, afirma o secretário estadual da Saúde, César Neves. “Além da forte tradição que possui, existe uma constante atualização dos exames oferecidos, por conta da grande variabilidade de patógenos que podem causar preocupação”.
Dos 568.537 exames realizados no âmbito do Sistema Único de Saúde (SUS) do Paraná, 513.451 foram derivados de amostras humanas analisadas nos Laboratórios de Epidemiologia e Controle de Doenças (DVLCD) do Lacen. As demais amostras (55.086) foram de água e produtos sujeitos ao controle sanitário, realizados nos Laboratórios de Vigilância Sanitária e Ambiental (DVLSA) e Laboratórios Regionais (Larens), também do Lacen.
Os dados evidenciam que as amostras para pesquisa de vírus respiratórios, arboviroses, carga viral de HIV, hepatites e contagem de leucócitos CD4/CD8, lideraram a lista de testagem no período. Dentre os exames feitos este ano, 654 foram de Sequenciamentos de Nova Geração (NGS) para tipagem de dengue, influenza, SARS-CoV-2, bactérias multirresistentes, tuberculose e estreptococos invasivos.
A equipe técnica de farmacêuticos, biólogos, biomédicos, enfermeiros e veterinários também realiza exames para coqueluche, difteria, doenças diarreicas, resistência bacteriana, meningites, tuberculose, doenças fúngicas, raiva, doenças zoonóticas, além da análise de alimentos, saneantes, medicamentos, cosméticos, ambientais e do Controle de Qualidade de Baciloscopia de Tuberculose e Hanseníase.
TRADIÇÃO – O Lacen Paraná completará 130 anos em 04 de dezembro. É o segundo laboratório mais antigo do Brasil. Localizado em São José dos Pinhais, na Região Metropolitana de Curitiba, conta inda com a Unidade de Fronteira, localizada, em Foz do Iguaçu, oito laboratórios regionais (Larens), distribuídos pelo Estado.
Além de atender todo o Paraná, o laboratório recebe amostras também de outros estados, como Rio Grande do Sul, Santa Catarina, Mato Grosso e Mato Grosso do Sul, para exames de bactérias resistentes a antibióticos.
Já para o estreptococos, bactéria que normalmente causa problemas na garganta ou na pele, podendo até causar choque séptico, o Lacen-PR presta serviço para todo o Brasil, apoiando outros estados.
“Outro fator importante é a capacitação dos nossos analistas, uma vez que grandes epidemias podem ser estimadas, mas nem sempre previstas”, enfatiza Célia Fagundes da Cruz, diretora do Lacen. “São mais de 100 pessoas, somente na unidade principal, entre servidores, bolsistas, residentes, estagiários e terceirizados, trabalhando em prol de um único objetivo. Se acrescentarmos os parceiros, esse número é muito maior. Entregamos um trabalho de excelência à população”.
REFERÊNCIA – O Lacen/PR é referência estadual para as demais Redes de Laboratórios do Estado. Atualmente, sua Divisão do Sistema Estadual de Laboratórios de Saúde Pública (DVSEL), atua na coordenação, aquisição de equipamentos e insumos, nas capacitações e treinamentos, e fornecimento de ensaios de proficiência aos laboratórios descentralizados.
Os Larens (unidades laboratoriais que ficam nas Regionais de Saúde) fazem análise de água e auxiliam na supervião dos laboratórios da rede SUS. O Lacen Paraná também fornece insumos para os laboratórios das universidades estaduais, que regionalizam o diagnóstico garantindo que o atendimento fique mais perto da população.